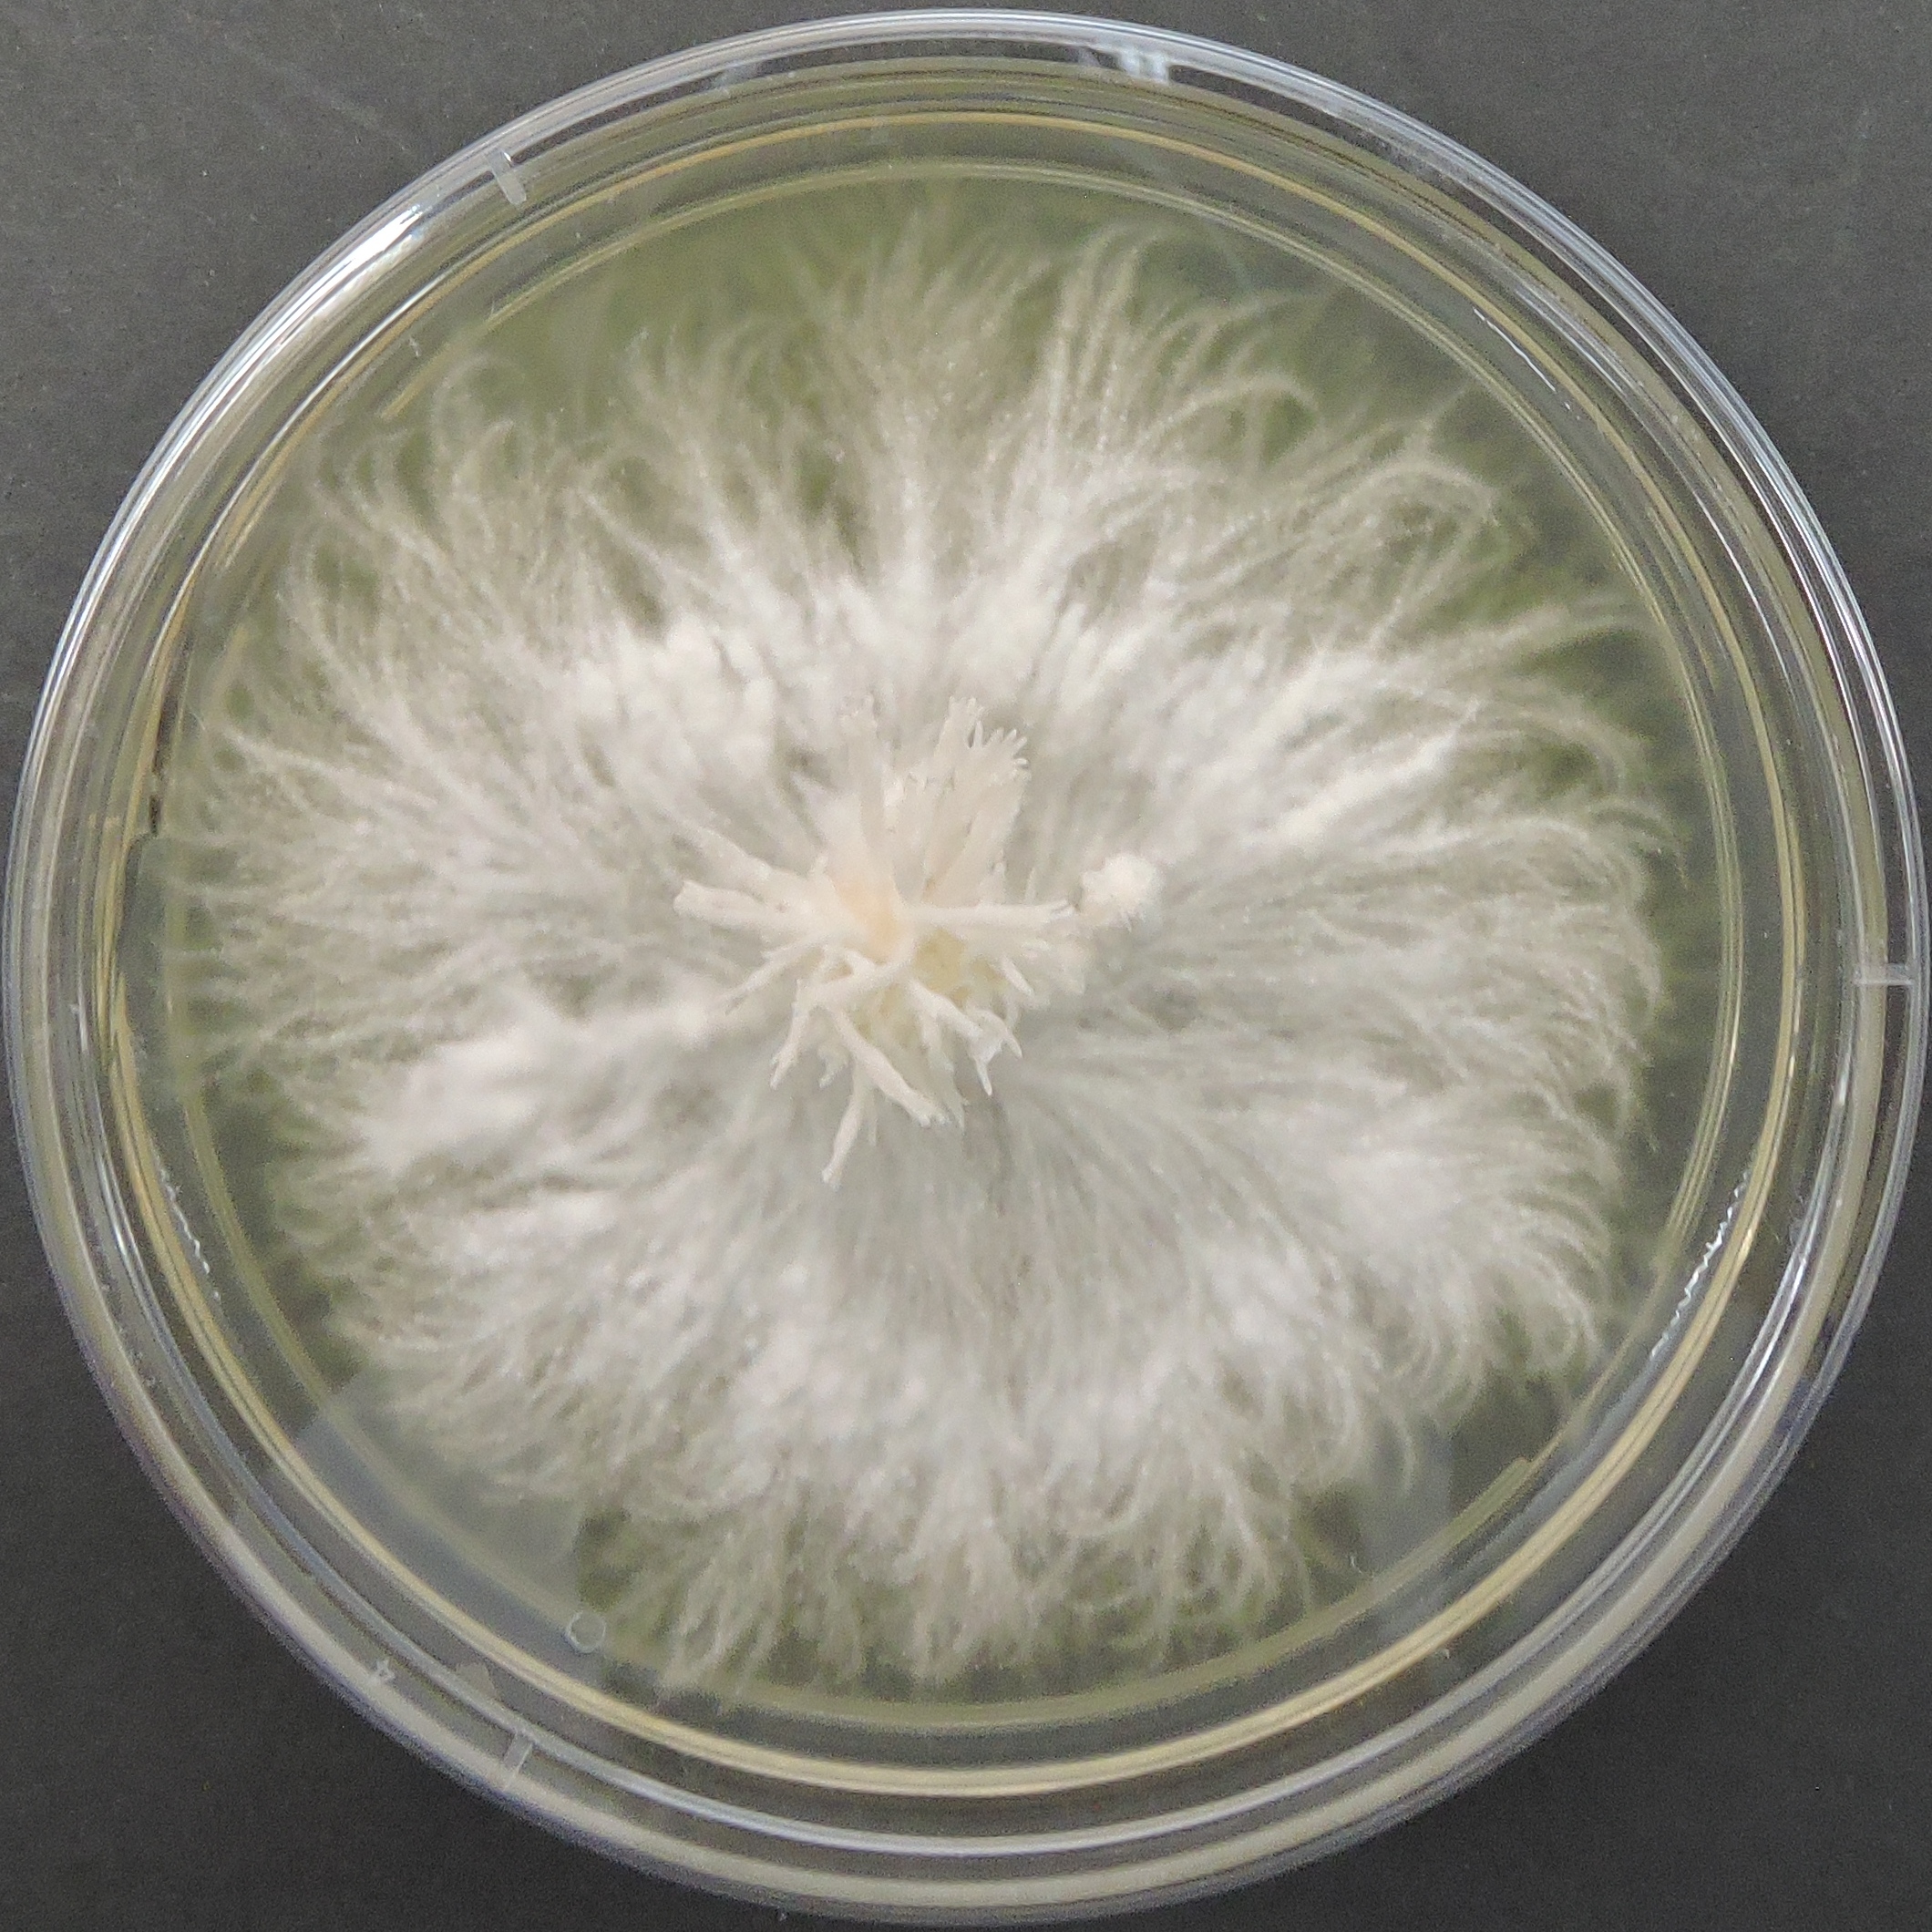
Lion's Mane Mushroom culture Plate (Hericium erinaceus)
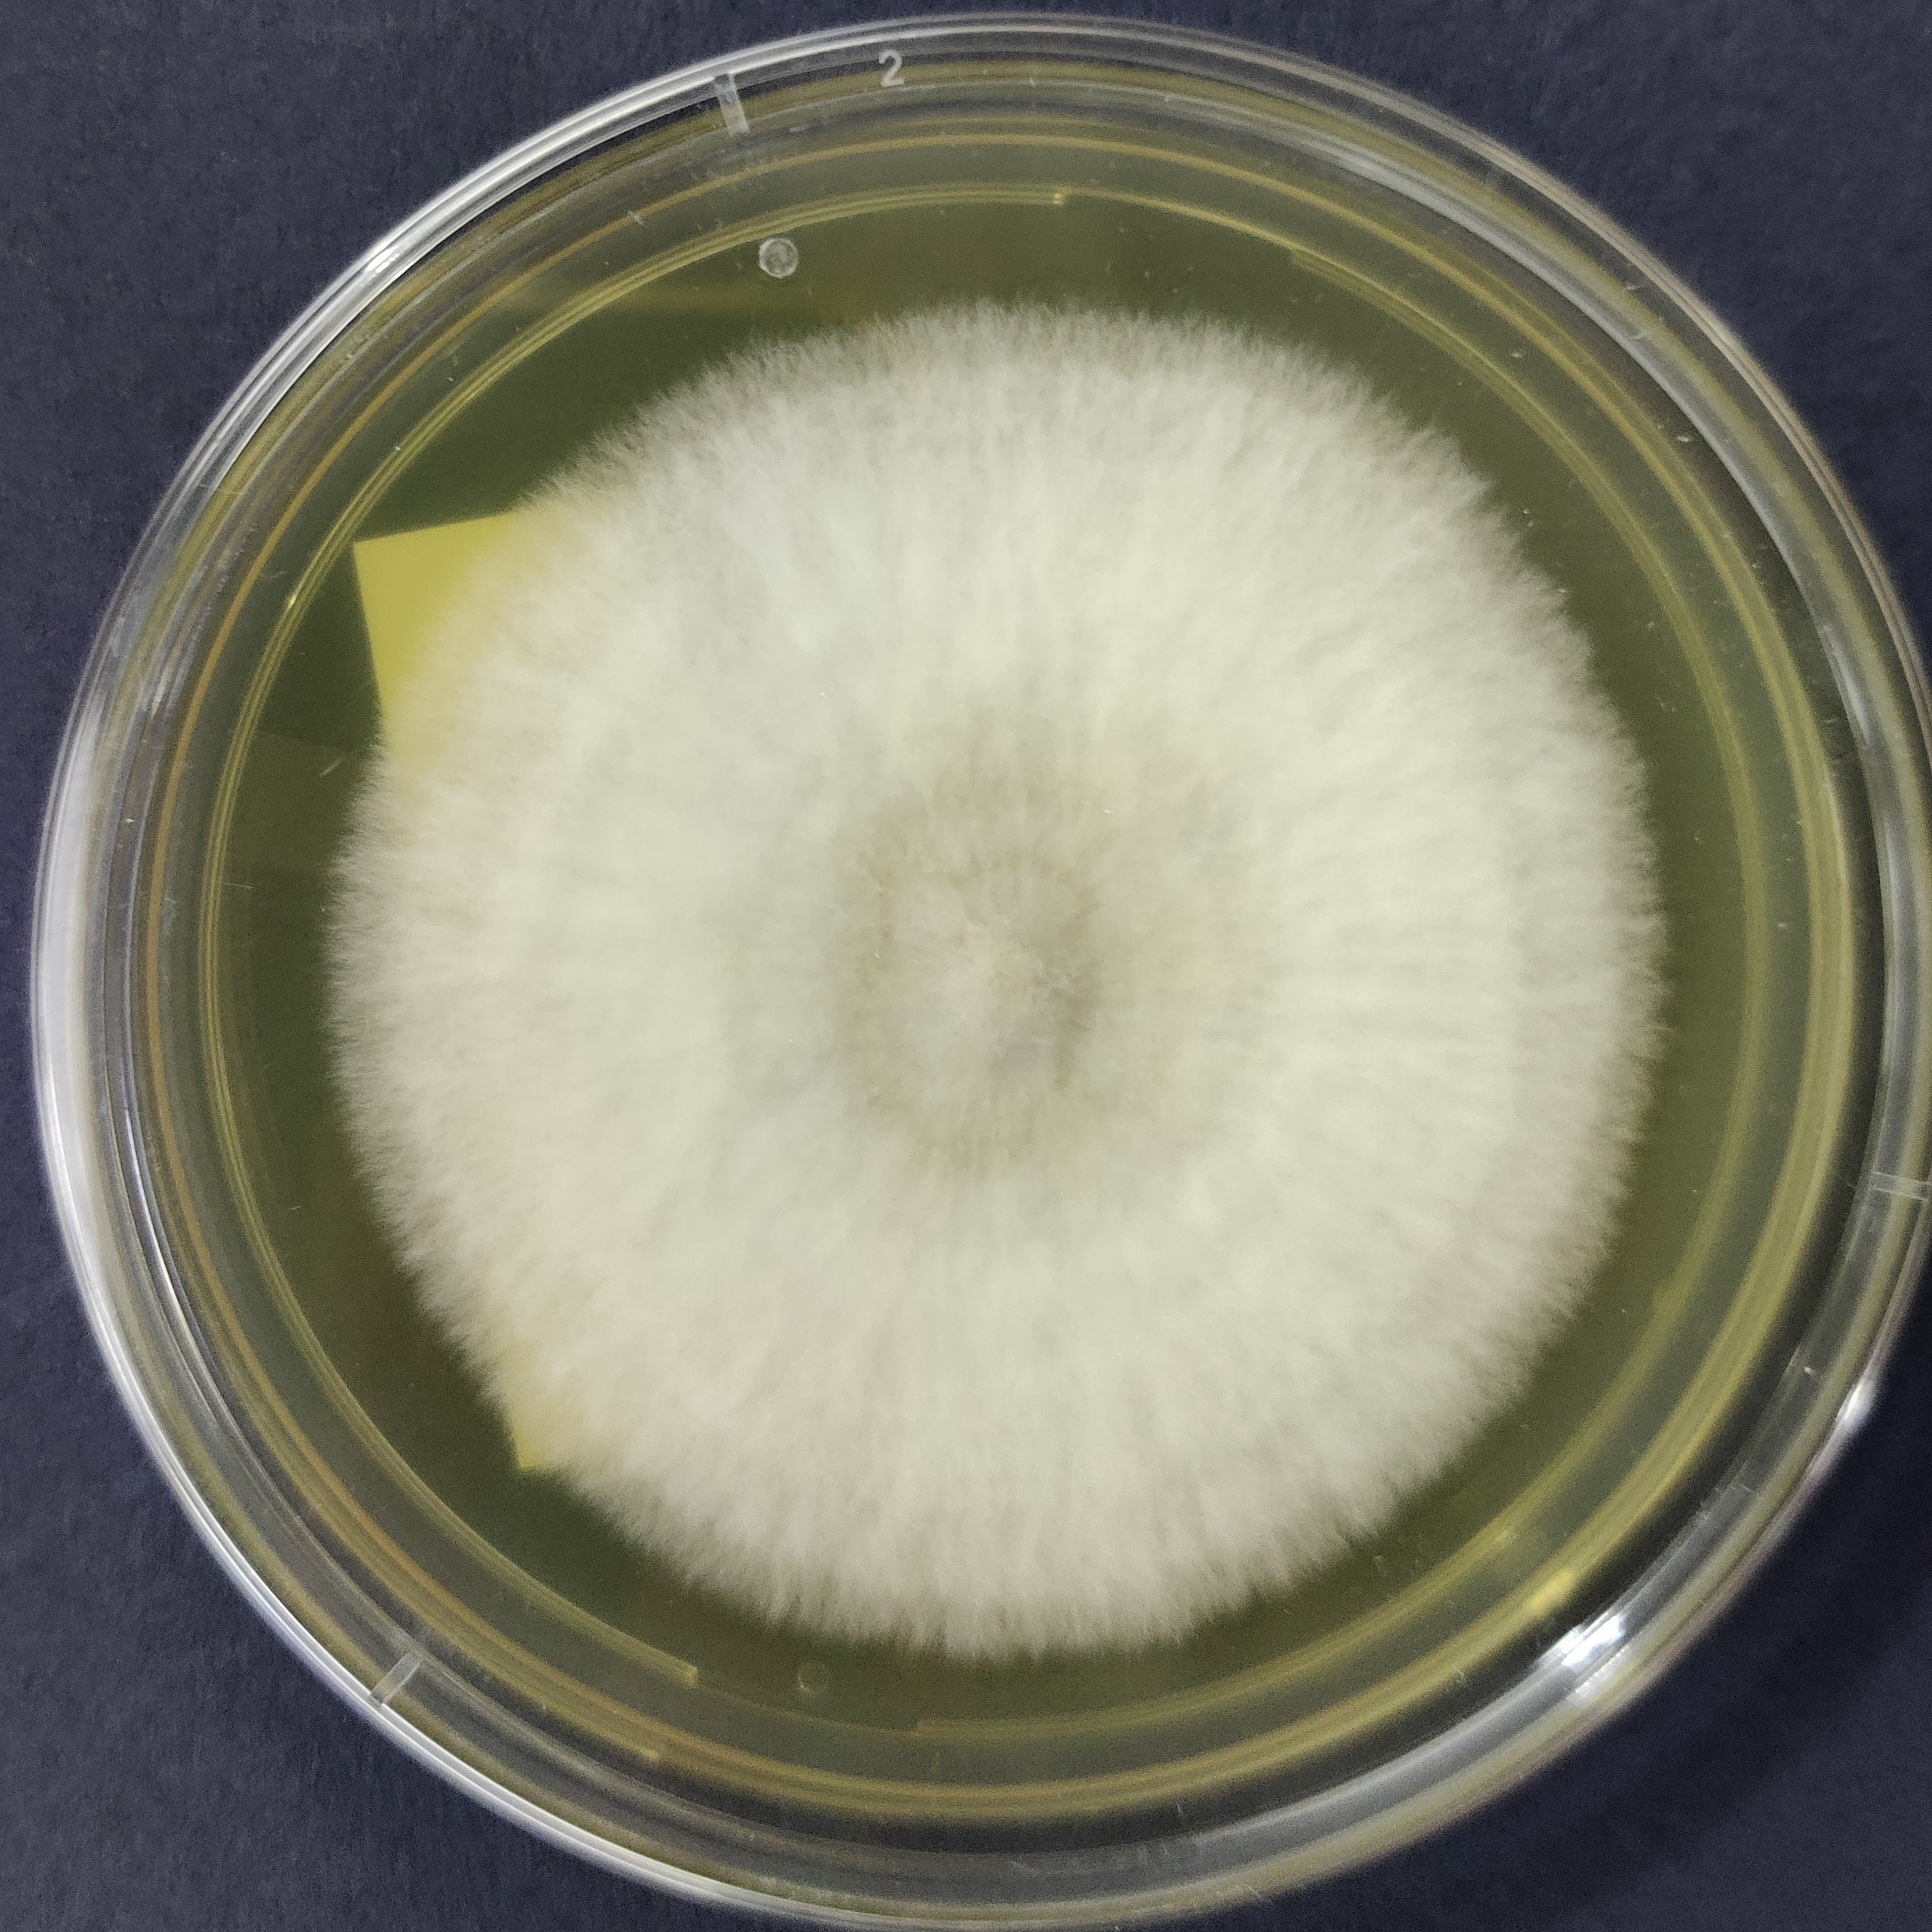
Shiitake Mushroom Pure Culture Plate (Lentinula edodes)

Cordyceps Capsules Keeda Jadi Mushroom Capsule
Support your health naturally with Cordyceps militaris (Keeda Jadi) capsules – a powerful Ayurvedic supplement known for boosting immunity, energy,
Select options
This product has multiple variants. The options may be chosen on the product page
Cordyceps militaris Culture Plate – commercial strain
Cordyceps mushroom Keeda Jadi Mushroom
Boost your vitality the natural way with Cordyceps militaris, also known as Keeda Jadi—a powerful medicinal mushroom long used in
Select options
This product has multiple variants. The options may be chosen on the product page
Cordyceps Mushroom Powder Keeda Jadi mushroom Powder
Boost your energy, stamina, and immunity with our premium Cordyceps mushroom powder (Keeda Jadi) powder. Sourced from lab-grown, high-quality cultures,
Select options
This product has multiple variants. The options may be chosen on the product page
Heat tolerant Lion’s mane Culture (Hericium erinaceus)
MUHSROOM CULTURE BANK PURE CULTURE - MEDICINAL MUSHROOMS PURE CULTURE - SPECIALTY MUSHROOMS All Products BESTSELLERS
Lentinula edodes Shiitake mushroom Culture Warm Weather
MUHSROOM CULTURE BANK PURE CULTURE - MEDICINAL MUSHROOMS PURE CULTURE - SPECIALTY MUSHROOMS All Products BESTSELLERS
Lion’s Mane Mushroom culture Plate (Hericium erinaceus)
Premium Cordyceps mushroom Keeda Jadi Mushroom (100 grams)
Reishi Mushroom Culture plate (Ganoderma lucidum)
Shiitake Mushroom Pure Culture Plate (Lentinula edodes)
MUHSROOM CULTURE BANK PURE CULTURE - MEDICINAL MUSHROOMS PURE CULTURE - SPECIALTY MUSHROOMS All Products BESTSELLERS